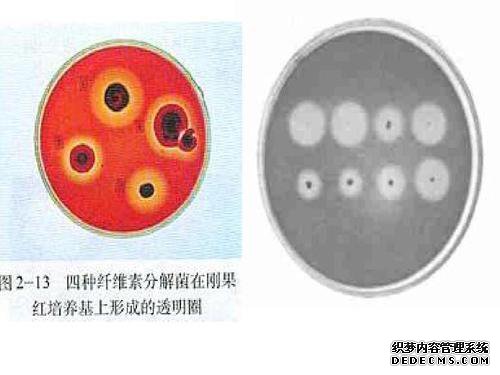

分离微生物降解微生物和降解微生物-降解纤维素的微生物的分离-教科书分析本课。
2)
3.分离降解纤维素2的微生物的教学设计。
3江西省新丰中学的微生物降解微生物分离教育设计-高级生物学教育计划(生物选修课)。
纤维素降解微生物的分离指导纤维素降解微生物的分离指导的设计单元2微生物培养及应用问题3分。
纤维素分解微生物的选择性分离1-2-3-选择性教育设计1-2-3降解纤维素的微生物的教育设计的分离_理化学生_中学教育_教育领域。
中学生物学选修课计划2微生物的培养和利用3降解纤维素的微生物的分离
生物选择12。
3分解降解纤维素的微生物(教育设计)
分解纤维素的三种微生物分离(教学设计)_两个物理和化学专业的学生_物理化学和化学专业的学生_高中。
主题3微生物降解微生物分离教学设计第3课微生物降解分离微生物教育设计教育计划-教育准备1
教育目标。
分解微生物的微生物1_降解纤维素的微生物的微生物降解图解1-降解纤维素的微生物的微生物1。
土壤中的纤维素。
高中生物学选择以下之一:2。
3“纤维素分解微生物的分离”高中生物学教育计划如下。2
3指导计划“分解纤维素的微生物的分离”-坟墓弦
生物学:选修科目1的新标准课程计划(降解纤维素的分离)生物学:选修科目1的新标准课程计划(降解纤维素的分离)-主题:微生物分解纤维素的目的是:(a)知识和技能简要描述从土壤中分离的纤维素酶的类型和作用。
分解微生物的微生物的分离分解纤维素的微生物的分离-分解纤维素JLSSYB的微生物的分离。